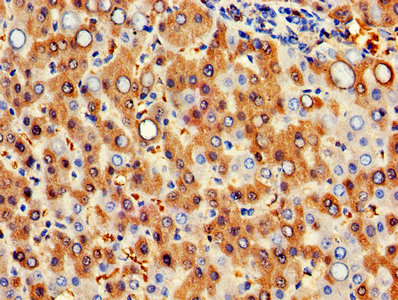

HBB Antibody
-
中文名稱:HBB兔多克隆抗體
-
貨號:CSB-PA010150LA01HU
-
規(guī)格:¥440
-
圖片:
-
Western Blot
Positive WB detected in: Rat liver tissue
All lanes: HBB antibody at 3µg/ml
Secondary
Goat polyclonal to rabbit IgG at 1/50000 dilution
Predicted band size: 16 kDa
Observed band size: 16 kDa -
IHC image of CSB-PA010150LA01HU diluted at 1:300 and staining in paraffin-embedded human placenta tissue performed on a Leica BondTM system. After dewaxing and hydration, antigen retrieval was mediated by high pressure in a citrate buffer (pH 6.0). Section was blocked with 10% normal goat serum 30min at RT. Then primary antibody (1% BSA) was incubated at 4°C overnight. The primary is detected by a biotinylated secondary antibody and visualized using an HRP conjugated SP system.
-
IHC image of CSB-PA010150LA01HU diluted at 1:300 and staining in paraffin-embedded human liver cancer performed on a Leica BondTM system. After dewaxing and hydration, antigen retrieval was mediated by high pressure in a citrate buffer (pH 6.0). Section was blocked with 10% normal goat serum 30min at RT. Then primary antibody (1% BSA) was incubated at 4°C overnight. The primary is detected by a biotinylated secondary antibody and visualized using an HRP conjugated SP system.
-
-
其他:
產(chǎn)品詳情
-
產(chǎn)品名稱:Rabbit anti-Homo sapiens (Human) HBB Polyclonal antibody
-
Uniprot No.:
-
基因名:
-
別名:Beta-globin antibody; HBB antibody; HBB_HUMAN antibody; Hemoglobin alpha chain antibody; Hemoglobin beta chain antibody; heterotetrameric hemoglobin antibody; Spinorphin antibody; subunit alpha antibody
-
宿主:Rabbit
-
反應(yīng)種屬:Human, Rat
-
免疫原:Recombinant Human Hemoglobin subunit beta protein (1-147AA)
-
免疫原種屬:Homo sapiens (Human)
-
標(biāo)記方式:Non-conjugated
本頁面中的產(chǎn)品,HBB Antibody (CSB-PA010150LA01HU),的標(biāo)記方式是Non-conjugated。對于HBB Antibody,我們還提供其他標(biāo)記。見下表:
-
克隆類型:Polyclonal
-
抗體亞型:IgG
-
純化方式:>95%, Protein G purified
-
濃度:It differs from different batches. Please contact us to confirm it.
-
保存緩沖液:Preservative: 0.03% Proclin 300
Constituents: 50% Glycerol, 0.01M PBS, PH 7.4 -
產(chǎn)品提供形式:Liquid
-
應(yīng)用范圍:ELISA, WB, IHC
-
推薦稀釋比:
Application Recommended Dilution WB 1:500-1:5000 IHC 1:200-1:500 -
Protocols:
-
儲存條件:Upon receipt, store at -20°C or -80°C. Avoid repeated freeze.
-
貨期:Basically, we can dispatch the products out in 1-3 working days after receiving your orders. Delivery time maybe differs from different purchasing way or location, please kindly consult your local distributors for specific delivery time.
-
用途:For Research Use Only. Not for use in diagnostic or therapeutic procedures.
相關(guān)產(chǎn)品
靶點(diǎn)詳情
-
功能:Involved in oxygen transport from the lung to the various peripheral tissues.; LVV-hemorphin-7 potentiates the activity of bradykinin, causing a decrease in blood pressure.; functions as an endogenous inhibitor of enkephalin-degrading enzymes such as DPP3, and as a selective antagonist of the P2RX3 receptor which is involved in pain signaling, these properties implicate it as a regulator of pain and inflammation.
-
基因功能參考文獻(xiàn):
- beta-globin is selectively deregulated in cancer cells, mediating a cytoprotective effect during blood-borne metastasis. PMID: 28181495
- Our finding suggested that a de novo nonsense mutation in ANK1 may be causative to HS which plays an important role in supplementing the mutational spectrum of the ANK1 and explaining the mechanism of HS. PMID: 29157167
- Studies indicate that beta-thalassemia and sickle cell disease (SCD) are both caused by mutations affecting the adult beta-globin gene. PMID: 29127676
- SNP-based classification of sickle cell anemia HBB haplotypes PMID: 28800727
- Upon oxygenation, changes in the conformational flexibility across different regions of alpha and beta globin chains in the tetrameric HbS molecule were investigated. It was observed that oxygenation led to perturbation in the conformation of several residues around the hydrophobic patch, groove of a tetramer and axial, lateral contacts across the double strands that are involved in HbS polymerization. PMID: 28465180
- a novel, positive role for PKR activation and eIF2alpha phosphorylation in human globin mRNA splicing, is reported. PMID: 28374749
- human bone marrow stromal cells-derived induced pluripotent stem sacs allow for more efficient erythroid cell generation with higher beta-globin production, likely due to heightened emergence of immature progenitors. PMID: 27739611
- study reports 3 novel HBB mutations - one in the promoter (-90 C>G), a 20 bp deletion in exon 2 (FS Cd 78/85) and a mutation in the donor site of intron 2 (IVS2:2 T>G); considering these novel mutations and the first observation of IVS1:6T>C, the molecular spectrum of beta-thalasemia in Mexicans comprises 21 different mutations, confirming the high allelic heterogeneity in Mexicans PMID: 28603845
- Embryonic stem cell sacs serve as hemangioblast-like progenitors capable to generate definitive erythroid cells that express beta-globin. PMID: 26866725
- Any alterations in the proximal CACCC and TATA boxes lead to a moderate decrease in synthesis of the beta-globin chain PMID: 28385923
- In conclusion, in this work we demonstrated that HBB is expressed by breast cancer cells, its expression is correlated with tumour aggressiveness in humans and its forced overexpression enhances breast cancer cell aggressiveness in vitro and in vivo. PMID: 28772282
- NF-E2, TAL1 and KLF1, all activators play a primary role in HSs formation in the LCR PMID: 27026582
- Five different beta-globin haplotypes were linked to sickle hemoglobin alleles in Mazandaran province. PMID: 28003571
- 2 cases of Polish patients with hereditary hemolytic anemia suspected of thalassemia were studied; identified 2 different frameshift mutations positioned in the third exon of HBB; results show a lack of natural stop codon due to the frameshift in exon 3 of beta-globin gene causes rapid degradation of its mRNA and indicate existence of novel surveillance pathway PMID: 28595636
- Our work suggested a novel function for HBB as a theranostic molecule: an innate antimetastasis factor with potential utility as an anticancer drug and a biomarker signaling the presence of clinically undetectable metastasis PMID: 27793844
- The presence of intravening sequence (IVS)-I-6 was significantly related with the development of extramedullary hematopoiesis in beta-thalassemia major patients. No other demographic or biological factor studied was found to be related with the presence of extramedullary hematopoiesis. PMID: 28399542
- we concluded that this novel beta-globin gene mutation was associated with the mild phenotype of beta-thal. PMID: 28475449
- We first report a novel beta chain variant, Hb Heze [beta144(HC1)Lys-->Arg; HBB: c.434A>G], in a Chinese family. Heterozygous inheritance of the mutation results in a mild beta-thalassemia (beta-thal) phenotype, whereas compound heterozygosity of Hb Heze with beta(0)-thal appears as the cause of beta-thal intermedia (beta-TI) in our case. PMID: 28366026
- Intracranial aneurysms are common in HbSS sickle cell disease. There was also a trend toward more common occurrence of aneurysmal subarachnoid hemorrhage in HbSS; women in the age group 30 to 39 years were most at risk. There was no correlation between the occurrence of intracranial aneurysms and moyamoya syndrome. PMID: 27301940
- the Fe-His bond of the beta subunits at alkaline pH causes a substantial increase in the change in global structure upon binding of CO to the beta subunit PMID: 28199095
- We screened for b-thalassemia-causing mutations by direct sequencing in different districts of West Bengal. Mutation detection was done using Sanger sequencing of the HBB gene. Results: A total of 14 different mutations were observed, including rare mutations IVS1-130(G>C), IVS1-129(A>C), -90(T>C), CD16(-C), -30(T>C), CD15(-T), and a novel mutation CD53(C>T). PMID: 27828729
- A report on the frequency and spectrum of beta globin gene mutations in thalassemia patients in a Pakistani population. PMID: 27263053
- Possession of a single HbS gene results in the generally harmless sickle cell trait (AS genotype) but inheritance of the HbS gene from both parents results in homozygous sickle cell (SS) disease which is often a severe condition destroying red blood cells rapidly and blocking flow in blood vessels with painful and often serious complications PMID: 26997009
- The TaqMan single nucleotide polymorphism (SNP) genotyping assays are a rapid, accurate, and cost-effective method for the initial screening of b-thalassemia cases, which will minimize the need for direct sequencing of the HBB gene, thus reducing detection costs and increasing throughput. PMID: 26890443
- Prevalence of hemoglobin E in Yunnan Province of Southwest China has been described. PMID: 26292035
- This study reports a Chinese family in whom the codon 35 (A > G) (HBB: c.107A > G) mutation of the beta-globin gene was not associated with the thalassemic phenotype previously described. PMID: 26754300
- Individuals with the HBB: c.*233G > C variant did not demonstrate any abnormalities in hematological parameters characteristic of beta-thal carrier state (17 heterozygotes) or clinical evidence of disease (homozygote). PMID: 26524961
- The profile of beta-thal mutations found in northern Brazil is different from those described in other regions of the country. PMID: 26372288
- Presented is a novel beta-thalassemia (beta-thal) mutation in a Chinese family. This mutation is located at -27 of the TATA box in the promoter of the HBB gene (HBB: c.-77A > G) and is associated with a phenotype of beta(+)-thalassemia (beta(+)-thal). PMID: 26554738
- These discoveries have suggested novel rational approaches for the beta-hemoglobin disorders including therapeutic genome editing PMID: 26375765
- The results we obtained did not reveal any correlation between genotype and phenotype among patients with beta-thalassemia. PMID: 25617386
- results suggest that KLF1 directly regulates the beta-globin gene, but probably has less direct impact on expression of the gamma-globin gene in fetal erythroblasts PMID: 26840243
- This study supports the hypothesis that Haemoglobin S confers resistance to hyperparasitaemia in patients exhibiting severe malaria syndromes. PMID: 26445879
- A new beta-globin variant causing beta-thalassemia has been confirmed as a founder effect in a Northern European (French) population. PMID: 25469539
- first description of Chinese individuals with the beta-thalassemia (beta-thal) mutation IVS-I-6 (T > C) (HBB: c.92 + 6T > C) which interferes with mRNA splicing and results in reducing expression of beta-globin chains that leads to a beta+-thal phenotype PMID: 25856402
- Sickle cell trait was protective against malaria. The HbAS group had fewer malaria episodes than the HbAA group. PMID: 23925429
- study of populations from eastern regions of India was undertaken to investigate genetic profile of heterogeneity in thalassemia patients; mutation analysis revealed the presence of 3 novel mutations: CD2 (-A) in the 1st exon, -42 (C-G), and -223 (T-C) in the promoter region of beta-globin gene PMID: 25976460
- The TG-beta-IVSI-6 mouse reproduces the molecular features of IVSI-6 beta-thalassemia and might be used as an in vivo model to characterize the effects of antisense oligodeoxynucleotides PMID: 26097845
- This study suggests that there is a significant association between certain polymorphic configurations of the beta globin cluster and the increase of HbF levels in healthy individuals. PMID: 21947948
- Twelve Hb Hofu heterozygotes and three sickle Hb Hofu compound heterozygotes have been found in eastern India carriers. PMID: 23889802
- we describe an integrative analytical process to identify specific CRISPR target sites in the human beta-globin gene (HBB) and predict their off-target effects. PMID: 25918715
- Prevalence of beta-globin mutations associated with beta thalassemia in Chinese populations. PMID: 25849334
- LIN28A over-expression increased HbF, reduced beta (sickle)-globin, and strongly suppressed all members of the let-7 family of miRNAs while reducing erythrocyte sickling. PMID: 25188417
- In septic patients, hemoglobin beta blood levels are related to the severity of sepsis. PMID: 25338941
- Structure of the human Hp-Hb and Trypanosoma brucei brucei HpHbR protein complex is described. PMID: 25410714
- Hemoglobin S is associated with a 70% reduction of harboring P. falciparum parasitemia at the heterozygous state; there was no equivalent protection with hemoglobin C. PMID: 25712976
- The previously described self-depurinating hotspot at codon 6 of beta-globin is unique to it, and is not found in other human globin genes. PMID: 26042536
- The study reports a new beta-globin chain variant: Hb Meylan [beta73(E17)Asp --> Phe; HBB: c.220G>T; c.221A>T]. The new variant results from a double nucleotide mutation at the same codon. The possible molecular mechanisms are discussed. PMID: 25476778
- This study reports a currently 3 years and 2 months old male patient with a homozygous codons 9/10 (+T) mutation on the beta-globin gene causing a beta-thal phenotype. PMID: 25572182
- The study reports Hb Feilding [beta12(A9)Thr --> Pro; HBB: c.37A>C]: a novel unstable beta-globin chain variant. PMID: 25572184
顯示更多
收起更多
-
相關(guān)疾病:Heinz body anemias (HEIBAN); Beta-thalassemia (B-THAL); Sickle cell anemia (SKCA); Beta-thalassemia, dominant, inclusion body type (B-THALIB)
-
蛋白家族:Globin family
-
組織特異性:Red blood cells.
-
數(shù)據(jù)庫鏈接:
Most popular with customers
-
-
YWHAB Recombinant Monoclonal Antibody
Applications: ELISA, WB, IHC, IF, FC
Species Reactivity: Human, Mouse, Rat
-
Phospho-YAP1 (S127) Recombinant Monoclonal Antibody
Applications: ELISA, WB, IHC
Species Reactivity: Human
-
-
-
-
-